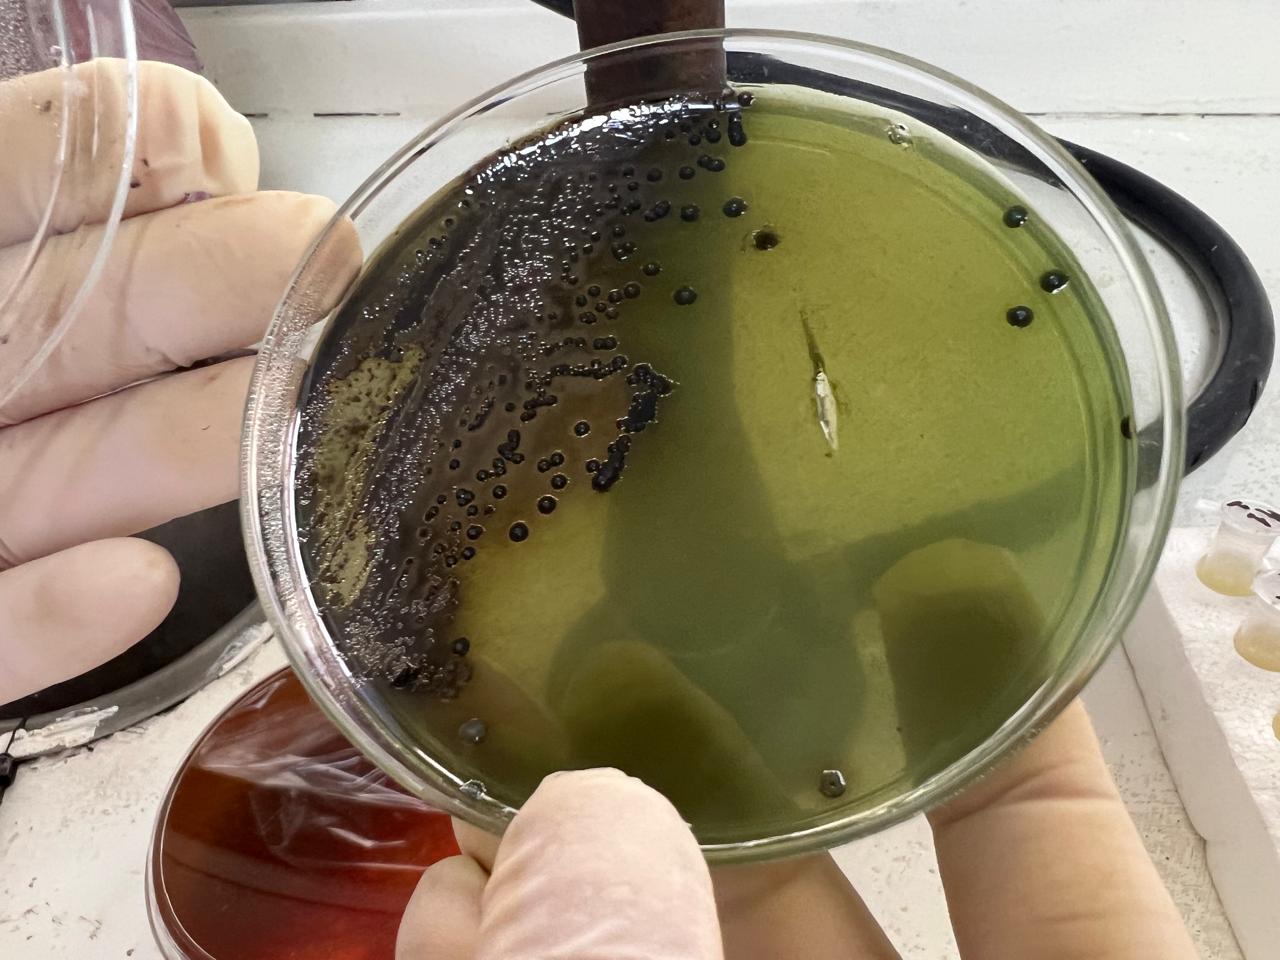
Desarrollo tipico de Salmonella spp. en agar Bismuto Sulfito desde una muestra de agua
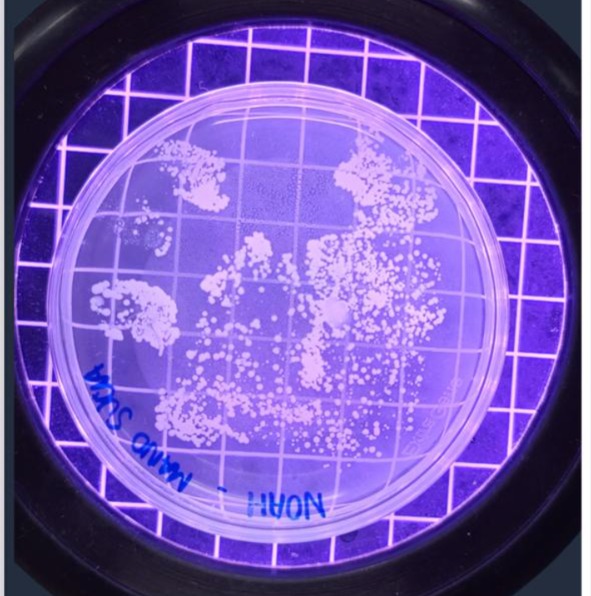
Desarrollo de microorganismos a partir de muestra de manos
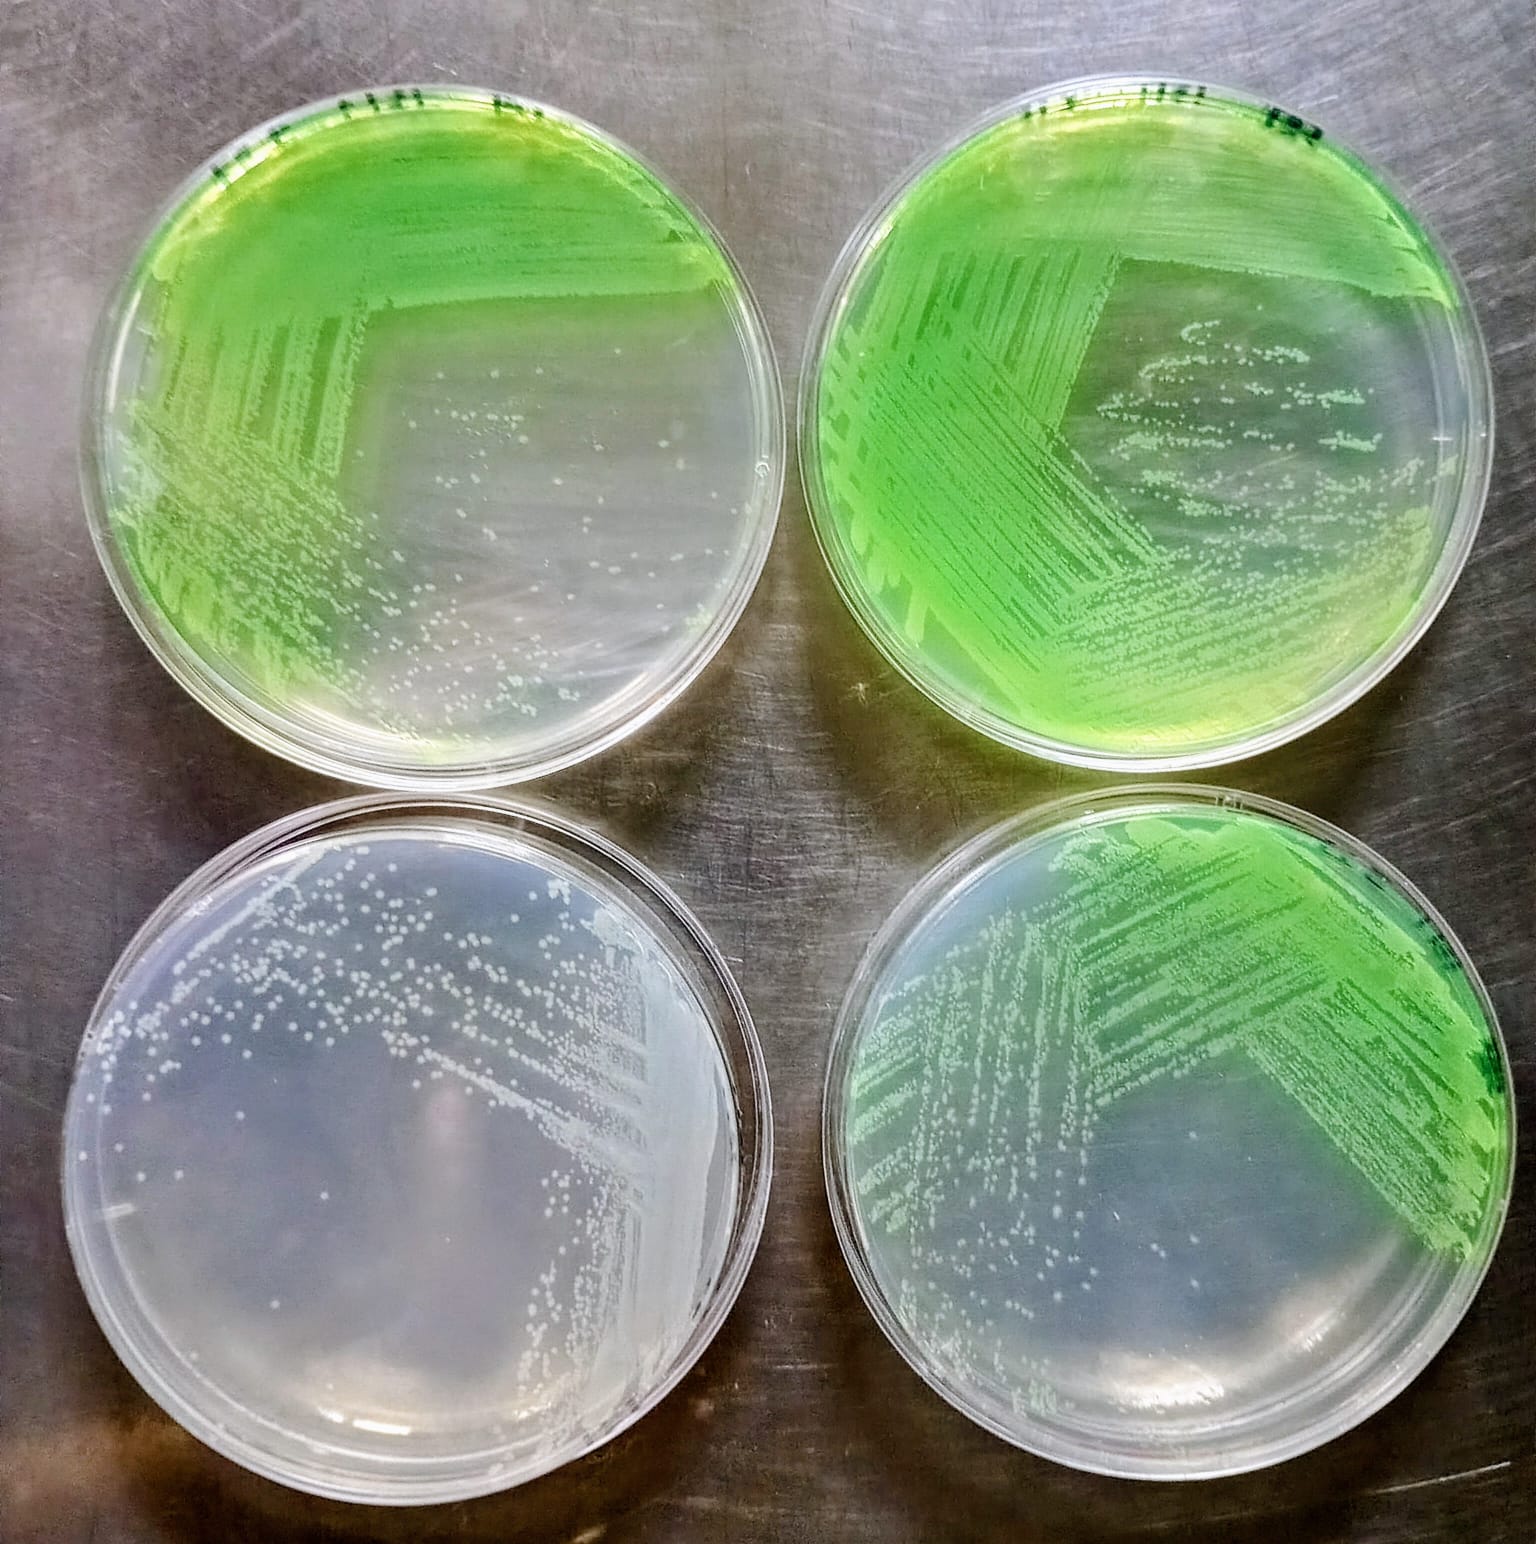
Desarrollo bacteriano en placas de agar Cetromide

ANÁLISIS MICROBIOLÓGICO DE AGUA Y ALIMENTO
(para consumo humano y animal)
El laboratorio realiza evaluaciones microbiológicas de diversos alimentos destinados al consumo humano y animal, así como de agua para distintos usos, determinando su aptitud para comercialización, consumo directo u otros fines.
El servicio está orientado tanto a establecimientos elaboradores de alimentos como a personas particulares. Asimismo, se llevan a cabo análisis de efluentes vertidos y controles microbiológicos de superficies, equipamientos, ambientes y manipuladores/as de alimentos.
Además de los análisis microbiológicos, el laboratorio brinda capacitaciones y asesoramiento técnico a empresas e instituciones, vinculados a higiene, inocuidad alimentaria, control microbiológico y buenas prácticas.
La determinación de aptitud sanitaria de agua y alimentos se efectúa conforme a los requisitos microbiológicos establecidos por el Código Alimentario Argentino, empleando metodologías internacionalmente reconocidas, tales como normas ISO y APHA, entre otras.
Se informa a continuación la conformación actual del equipo de trabajo:
RESPONSABLES
• Dra. Juliana González – Profesora Adjunta y docente responsable de los cursos Microbiología de los Alimentos (Lic. en Tecnología de los Alimentos) y Microbiología Alimentaria y Análisis de Alimentos (Orientación Tecnología de los Alimentos – Medicina Veterinaria). Investigadora Adjunta del CIVETAN-CONICET.
• Dra. María Victoria Vélez – Docente participante de los cursos mencionados e Investigadora Asistente del CIVETAN-CIC.
• Mariana Gigampa – Personal nodocente del Departamento de Calidad y Tecnología de los Alimentos.


Reacción típica de P. aeruginosa en agar F
Desarrollo tipico de Salmonella spp. en agar Bismuto Sulfito desde una muestra de agua

Procesamiento de muestras de salsa de tomate

Desarrollo en agar EMB

Desarrollo de mohos y levaduras de muestra de aire de un establecimiento elaborador de alimentos

Desarrollo tipico de E. coli en agar Hektoen
Desarrollo de microorganismos a partir de muestra de manos

Desarrollo de microorganismos mesofilos aerobios
Desarrollo bacteriano en placas de agar Cetromide

Desarrollo bacteriano en agar P

Crecimiento típico de Salmonella spp. en agar TSI




